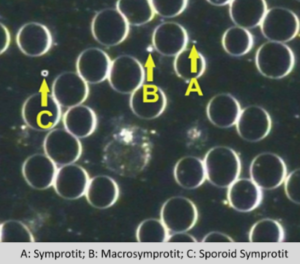

Short Description
The symprotit is considered the smallest living unit within the pleomorphic model. It appears as tiny, bright particles in the plasma and serves as the foundation for all later forms. Symprotits may join together into chains or clusters and eventually develop into more complex structures. Their behaviour reflects the overall condition of the biological terrain.
Pleomorphic Perspective
Symprotits (and macrosymprotits and sporoid symprotits) can be found in the plasma, RBCs and WBCs. In darkfield analysis we usually observe the pathogenesis of the primary parasite progressing according to a basic pattern. This pattern is as follows: the symprotit develops inside a cell into the higher form, namely the chondrit, which then evolves into an ascit (Leptotrichia buccalis) by going through various intermediate forms.
Implications
- Symprotits can be symbiotic regulators in the body or can be pathogenically programmed.
- The degree of variation in size of the reflective spheres in darkfield (symprotits, macrosymprotits, sporoid symprotits) is a clue to the extent of upward development of the endobiont.
- High numbers of symprotits can be an indication of inflammation.
- High numbers and many different sizes can be indicative of an acute infection.
Interventions
Any combination of the following, depending on the rest of the case:
IMMUNE PROTOCOL:
- Immucil + HumiCaps + NeoFlora
INFLAMMATION PROTOCOL:
- HumiCaps: 2-4 capsules 2-4x daily.
- Glutathione 1 capsule 1-2x daily.
- Trace minerals: Bio-lonic Mineral Concentrate
- Omega-3 supplement (1000-2000 EPA daily
SUPPLEMENTS:
- Immune supporting nutritionals, such as Calcium ascorbate (2g 2xdaily), Zinc, N-Acetyl-Cysteine, proanthocyanidins & astaxanthin.
- Trace minerals: Bio-lonic Minerals.